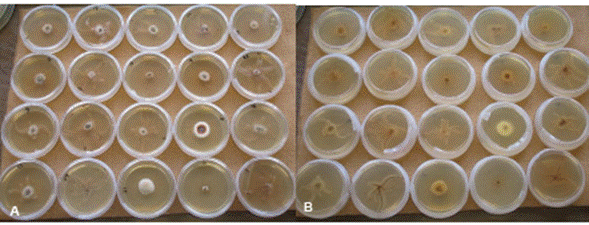

Introducción
En México se cosecharon 1.64 millones de ton de aguacate en 2023 lo que representa el 31% de la producción mundial con 179,914.30 ha sembradas. De esta superficie, Michoacán contribuye con 992,816 ton para exportación a EUA, China, Corea, y Chile (SIAP, 2023). El hongo Armillaria spp se ha registrado en ecosistemas forestales, frutales y arbolado urbano (Baumgartner, 2004). Árboles estresados por agentes bióticos o abióticos son más susceptibles a Armillaria, particularmente en áreas donde la superficie forestal ha sido sustituida por cultivos comerciales (Valdez et al. 2004). Estudios recientes de este patógeno describen algunas especies como A. mellea, A. ostoyae y A. mexicana en durazno (Prunus sp) y A. mellea en forestales (Elías, 2018).
Armillaria se ha registrado en Michoacán en algunos cultivos como Prunus pérsica y Persea americana, en este último se desconoce la especie (Téliz y Mora 2015). En durazno se reporta a A. mellea, A. gallica y A. mexicana en Coatepec Harinas y Temascaltepec, Estado de México (Elías, 2018). Las especies presentes en árboles forestales son A. calvescens, A. gallica, A. mellea, y A. ostoyae reportadas en Chihuahua, Durango, Estado de México, Guanajuato, Jalisco, Nuevo León, Puebla, Querétaro, Veracruz, y Morelos (Alvarado et al., 2007). Entre las diferentes técnicas para identificar especies con poca variación morfológica destacan la compatibilidad somática y análisis molecular (Schulze et al.1997; Worrall, 1994; White et al. 1990). A nivel molecular, el factor de elongación TEF-1α se ha empleado por su utilidad filogenética y ser una region conservada (Hasegawa et al. 2010). Maphosa y colaboradores (2006) utilizaron este gen para estudios filogenéticos de Armillaria y lograron establecer la relación entre especies de Armillaria de los hemisferios norte y sur. El objetivo de esta investigación fue identificar molecularmente las especies de Armillaria asociadas con pudrición de raíz y marchitez del aguacate en el estado de Michoacán.
Muestreo y procesamiento de raíces y tejidos infectados. Se colectaron raíces con presencia de micelio de Armillaria spp. de 20 árboles de aguacate de tres huertos comerciales de los municipios de Charapan, Los Reyes, y Nuevo Parangaricutiro, Michoacán. Un total de 60 muestras se trasladaron al laboratorio para aislar al hongo. El micelio se fragmentó y se desinfestó en una solución de hipoclorito de sodio al 3% y etanol al 70% durante 10 y 5 min, respectivamente. Entre cada solución se realizó un enjuague con agua destilada estéril para posteriormente secar los trozos de micelio en sanitas estériles (Aguín et al. 2004).
Aislamiento y conservación de las cepas. Un total de 60 aislamientos se obtuvieron de siembras en cajas de Petri con medio BDS (extracto de malta (AM) con 40 mg de benomyl, 20 mg de dicloran, y 100 mg de estreptomicina) (Aguín et al. 2004). En cada caja se colocaron cinco fragmentos de micelio y se mantuvieron a 24°C en oscuridad hasta que el hongo empezó a desarrollar rizomorfos (un mes aproximadamente). La conservación de las cepas se hizo en VCAM (Very Cold Armillaria Medium: 1.5% agar, 0.75% extracto de malta, 0.5% peptona, and 0.75% dextrosa) con cinco réplicas por cepa.
Extracción de ADN y PCR. El DNA se extrajo a partir de cepas de tres semanas de edad cultivadas en extracto de malta al 1% (Figura 1), siguiendo el protocolo de Cenis (2009).
Figura 1 Morfotipos de Armillaria obtenidos de huertas de aguacate de diferentes municipios de la franja aguacatera de Michoacán. A. Anverso, B. Reverso.
La concentración y absorbancia del DNA se cuantificaron en el Nanodrop 2000c Spectrophotometrer®. Se amplificaron regiones de los genes tef 1-a y rpb2. Para el factor de elongación tef 1-α se utilizaron los iniciadores EF1160R (5’CCGATCTTGTAGACGTCCTG3’) y EFR595F (5´CGTGACTTCATCAAGAACATG3´) (Maphosa et al., 2006) y RPB2-6F (5´ TGGGGKWTGGTYTGYCCTGC 3´) y RPB2-7R (5´ CCCATWGCYTGCTTMCCCAT 3´) para el gen rpb2 (Brazee et al., 2011). Las reacciones PCR se realizaron en un volumen total de 25 µL con 10 mM de Buffer Tris-HCl pH 8.0, 50 mM KCl, 1.5 µM MgCl2, 25 mM de cada uno de los dNTP’s, 0.2 U de Taq DNA polimerasa, 10 pM de cada uno de los oligos (Invitro-gen, USA) y 25 µg de DNA genómico. Las reacciones de PCR se realizaron en un termociclador Veriti® 96-Well Thermical Cycler (Applied Biosystems, USA). El programa consistió de un ciclo de desnaturalización inicial a 94°C por 2 min, 30 ciclos de desnaturalización a 94°C por 30 seg, alineamiento a 56° por 30 seg, extensión a 72° por 30 seg y elongación final a 72° por 7 min para el factor de elongación. Para el gen rpb2 el primer ciclo fue de 95 °C durante 2 min, posteriormente se realizaron 30 ciclos que comprendían una desnaturalización a 94 °C durante 30 s, una temperatura de alineamiento de 60 °C durante 45 s, y una extensión de 72 °C durante 1 min y una extensión final a 72 °C durante 10 min (Brazee et al., 2011). Los amplicones generados se examinaron en un gel de agarosa al 2% (p/v) teñido con SYBER Green (Invitrogen, USA). Los productos de amplificación obtenidos fueron secuenciados por la empresa Elim Biopharmaceuticals Inc. (Hayward, CA. USA). Las secuencias obtenidas se editaron a mano para eliminar las ambigüedades en los extremos y se realizó una búsqueda Blast para encontrar aquellas con máxima identidad con secuencias del NCBI Genbank. Se obtuvieron los archivos fasta de secuencias de Armillaria spp. y de aquellas con mayor homología para realizar análisis filogenético, incluyendo una secuencia de Desarmillaria tabescens (KY359140) para su uso como grupo externo. Se realizó alineamiento de secuencias con MAFFT con los parámetros por default (Katoh et al., 2017). El alineamiento obtenido se utilizó para obtener un modelo evolutivo empleando el software ModelFinder (Kalyaanamoorthy et al., 2017). Los árboles filogenéticos se generaron empleando los modelos TIM3e+G4 (gen de factor de alargamiento) y GTR+G (gen rpb2) para calcular las distancias genéticas. Se generaron dendrogramas mediante el criterio ML en IQ-TREE (Nguyen et al., 2015). Se obtuvieron los valores SH-aLRT (%), aBayes support, y ultrafast bootstrap (UFBoot) support para cada bifuración. Debido a la congruencia entre los tres valores de soporte solo se incluyeron en el árbol los porcentajes de SH-aLRT mayores al 50%. Lo árboles se visualizaron y editaron empleando el software FigTree version 1.4.2 (http://tree. bio.ed.ac.uk/software/figtree/).
Amplificación de los genes rpb2, tef α-1 y filogenia. Con la amplificación del gen tef α-1 se obtuvo una banda de 450 a 500 pb. La cepa MICH29 colectada en Charapan se identificó como A. gallica de acuerdo con BLAST y los caracteres morfológicos de los basidiocarpos (Figura 2).
El alineamiento con secuencias del GenBank mostró 99% de similitud con la secuencia JF895870 correspondiente a A. gallica (Brazee et al. 2011) (Figura 3).
Esta especie se ha reportado en Norte América y se encuentra estrechamente relacionada con A. calvescens . A. gallica está reportada en especies forestales de México (Alvarado et al., 2007) y durazno (Elías, 2018). Sin embargo, este es el primer reporte de A. gallica asociada a la pudrición de raíz en aguacate en Michoacán. La cepa MICH32 y MICH32R se alineó con A. mexicana, aunque no existen secuencias del gen RPB2 para esta especie. La cepa 21 originaria de San Juan Viejo se situó de manera independiente entre el clado de A. mellea y A. mexicana; el

Figura 2 Basidiocarpos de Armillaria gallica colectados en Charapan, Michoacán. A. Basidiocarpos maduros de Armillaria gallica (píleo amarillo con escamas); B. Basidiocarpos de A. gallica inmaduros con coloración grisácea y escamas; C. Basidiocarpo solitario con rizomorfo en la base.
porcentaje de alineamiento con estas especies fue de 62% y 66%, respectivamente. Esta especie por tanto no pudo identificarse. Es probable que exista una relación entre estas especies; sin embargo, para esta cepa en particular es necesario realizar la descripción morfológica y filogenia multigen que incluya la amplificación de al menos tres genes (p.e., ITS, TEF y RPB2). No se puede descartar que debido a la heterogenicidad y poca variación en este gen resulte complicado diferenciar entre algunas especies (Hasegawa et al. 2010).
Las secuencias alineadas con factor de elongación, tef 1-α, que mencionan Maphosa y colaboradores (2006) sirven para analizar la relación entre especies e identificarlas (Hasegawa et al. 2010). El aislado MICH29 es el único que se agrupó en el clado de A. gallica con 100% de identidad respecto a la base de datos del GenBank y un fragmento amplificado entre 600 y 700 pb que es el rango de fragmento obtenido para Armillaria utilizando el factor de elongación (Hasegawa et al. 2010; Maphosa et al. 2006). Con la cepa MICH21, los resultados fueron más consistentes, Armillaria sp se agrupó en un clado situado entre A. mexicana y A. mellea. La relación entre los clados podría deberse a que el hemisferio sur podría ser el origen del ancestro de Armillaria spp (Maphosa et al., 2006).
Los resultados del alineamiento y análisis filogenético del gen TEF α-1, corroboran que la relación entre especies de Armillaria es muy estrecha y que se tienen que considerar otros parámetros para distinguirlas, por ejemplo, el morfológico. Algunas especies están significativamente ligadas y la amplificación de ITS no es suficiente para distinguirlas (Coetzee et al. 2001). Con este gen, las especies de Armillaria del hemisferio norte se estuvieron estrechamente relacionadas (Dunne et al. 2002). Este hecho está relacionado con la hibridación interespecífica como ocurre con A. gallica y A. calvescens, donde ambas especies son parcialmente infértiles

Figura 3 Análisis filogenético con secuencias de especies de Armillaria provenientes de aguacate y del GenBank amplificadas con el gen tef α-1. El aislado MICH29 se agrupó directamente con la especie Armillaria gallica. Las cepas MICH32 y MICH32R están estrechamente relacionadas con Armillaria mexicana, mientras que MICH21 se agrupó entre el clado de A. mellea y A. mexicana.
y por eso hay compatibilidad de talos. Aunque los IGS e ITS son las regiones más amplificadas para este género no son confiables por que se presentan casos en donde no se pueden distinguir las especies, debido a la alta diversidad de los IGS entre aislados.
Con el presente estudio se amplía la distribución geográfica de A. gallica a Michoacán, además de los registros previos en Chihuahua, Durango, Estado de México, Guanajuato, Jalisco, Nuevo León, Puebla, Querétaro, Veracruz, Morelos (Elías, 2017). Respecto al gen rpb2 no hay secuencias de todas las especies en Genbank; sin embargo, la secuencia de la cepa MICH29 se alineó 100% con A. gallica. La cepa MICH21 se alineó con el clado de A. mellea (Figura 4).
La amplificación del gen rpb2 ha sido útil en la discriminación de especies de basidiomicetos estrechamente relacionadas. No obstante, este gen no discriminó entre las especies A. calvescens y A. gallica (Brazee et al., 2011). Al presente, el gen rpb2 se ha empleado poco para examinar especies estrechamente relacionadas de Armillaria pero a comparación de las secuencias IGS e ITS se han utilizado en varios estudios filogenéticos. Regiones de ADNr también proporcionan una resolución deficiente para distinguir especies estrechamente relacionadas de Armillaria (Ota et al., 2011; Kim et al., 2006). Además, los micelios diploides a menudo contienen secuencias heterogéneas que pueden confundir el análisis (McLaughlin y Hsiang; 2010; Kim et al., 2006).
Conclusiones
Se encontraron tres especies de Armillaria presentes en huertos de aguacate establecidos en suelos con antecedente forestal en Michoacán. A. gallica se identificó en siete de 10 muestras con síntomas más severos de pudrición de raíz en comparación con las otras dos especies identificadas. A. mexicana se detectó 25% de las muestras y una especie no identificada, Armillaria sp, en 55%. Factor de elongación fue el gen más adecuado para identificar especies de Armillaria. Se sugiere explorar otros genes para generar una filogenia concatenada. La identificación morfológica de especies de Armillaria es complicada debido a los caracteres estrechos entre especies. Es necesario fundamentar los resultados moleculares con datos morfológicos.










texto en 



